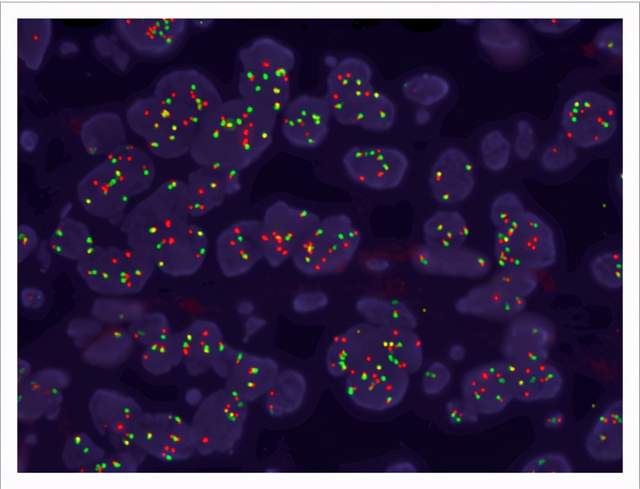
85),并通过荧光原位杂交(fish)进行了确认.

FISH荧光原位杂交

荧光原位杂交(fish)
图片尺寸1645x1342
图表4:荧光原位杂交(fish)技术
图片尺寸640x533
fish荧光原位杂交系统
图片尺寸2748x2200
荧光原位杂交技术fish
图片尺寸674x456
荧光免疫原位杂交fish
图片尺寸600x395
做羊膜腔穿刺手术后能不能尽早知道胎儿是否正常?
图片尺寸962x642
荧光原位杂交技术fish
图片尺寸554x407
荧光原位杂交(fish)技术攻略
图片尺寸712x286
fish免疫荧光原位杂交技术
图片尺寸927x471
荧光原位杂交( 荧光原位杂交(fish) 基因组探针的分离 利用原位杂交
图片尺寸1080x810
rna荧光原位杂交(rna-fish)
图片尺寸800x863
视频回放荧光原位杂交fish全切片扫描与分析应用
图片尺寸2000x1125
fish技术荧光原位杂交技术
图片尺寸600x422
荧光原位杂交fish试剂盒
图片尺寸500x334
荧光原位杂交技术在产前诊断中的应用
图片尺寸623x520
85),并通过荧光原位杂交(fish)进行了确认.
图片尺寸640x489
dna荧光原位杂交dnafish
图片尺寸1023x1023
荧光原位杂交技术(fish)的基本原理及应用
图片尺寸630x383
fish荧光原位杂交结果出来了怎么判断是几号染色体
图片尺寸303x418
荧光原位杂交实验 fishppt
图片尺寸1080x810